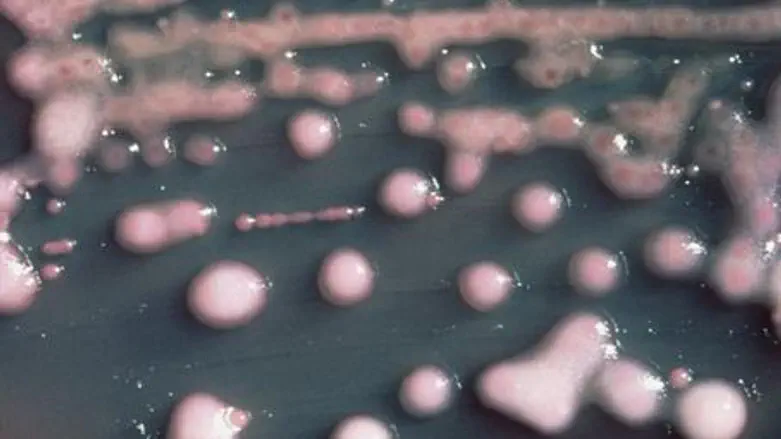
Klebsiella pneumoniae bacteria

The death of a premature baby boy at the Sheba Medical Center at Tel HaShomer Hospital in Tel Aviv has led to the temporary closure of its neonatal intensive care unit (NICU) to other, incoming patients.
The blood of the baby, born at 26 weeks' gestation, was discovered after he died to have been infected with Klebsiella bacteria.
A second premature infant was also found to have been infected, but is in stable condition. Five more have been diagnosed as carriers, and two others were infected but have since recovered – all within the past month.
Hospital staff has maintained close contact with the parents as they work to deal with the situation and heal their small patients. A hospital official said the staff immediately tested all children in the unit as soon as the first case was detected. They isolated those infants who were found to be carriers or infected with the bacteria from the uninfected babies and those who were not carriers.
Klebsiella can cause different types of healthcare-associated infections, including pneumonia, bloodstream infections, wound or surgical site infections, and meningitis.
According to the U.S. Centers for Disease Control (CDC) the bacteria have increasingly developed antimicrobial resistance. Unfortunately they have recently become resistant to the class of antibiotics known as carbapenems which are often the last line of defense against Klebsiella.
The bacteria are normally found in the human intestines – where they do not cause disease – and are also found in human stool (feces).
In hospitals and other health care settings, Klebsiella infections commonly occur among sick patients who are receiving treatment for other conditions and who are using devices such as ventilators, IV catheters or who are taking long courses of antibiotics.
The bacteria is spread through person-to-person contact and sometimes by contamination of the environment, but not through the air.